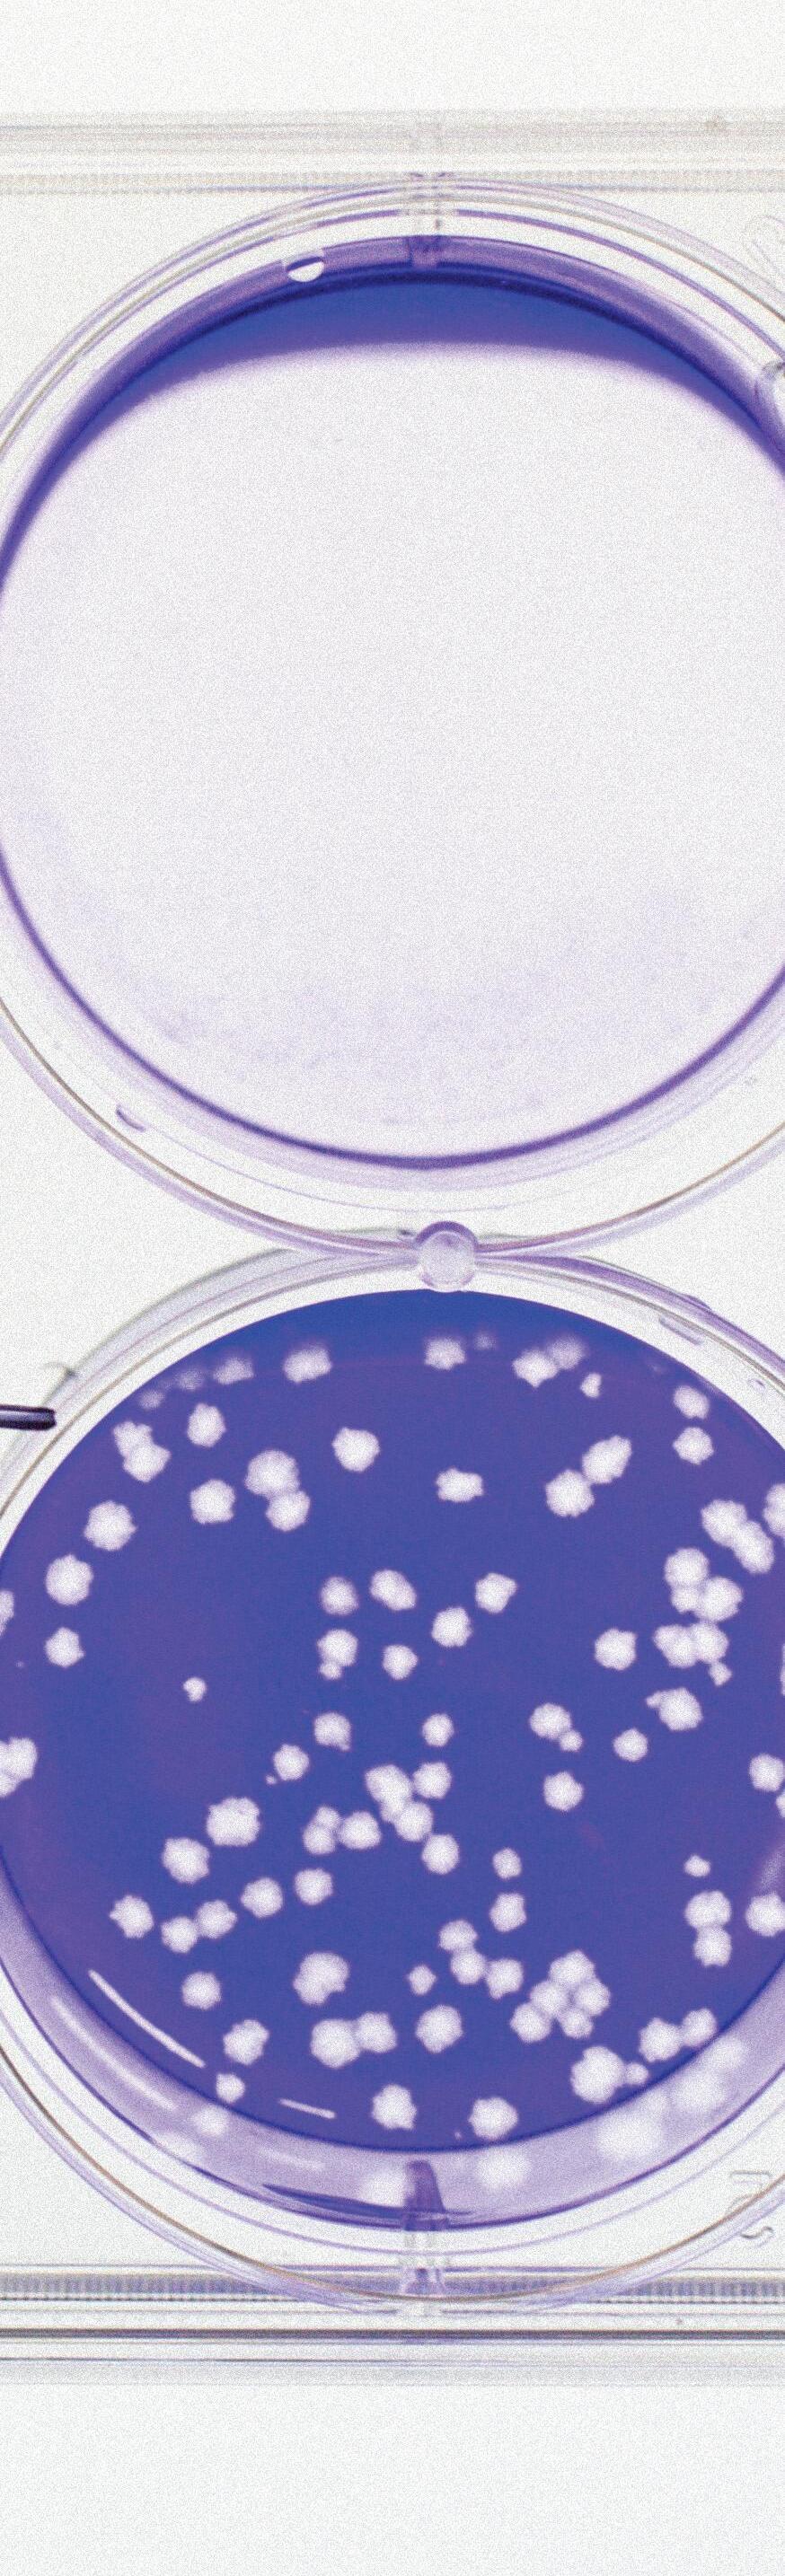

A world-class research institute


making a profound impact on society

![]()




making a profound impact on society

State University is a unique scientific community where experts from biology, physics, chemistry, engineering, mathematics, sustainability and other fields come together to collaborate across boundaries. Our collective goal is to tackle the world’s pressing challenges and find solutions inspired by nature, all aimed at enhancing life on our planet.
From searching for a cure for Ebola to removing harmful chemicals from water and creating innovative diagnostic tools for measuring radiation exposure, the scientists at the Biodesign Institute draw their inspiration directly from the natural world.

At the Biodesign Institute, our focus goes beyond complex questions to practical applications and viable solutions to today’s challenges that face humanity:
• How can we detect diseases earlier?
• How can we eliminate the threat of cancer, Alzheimer’s, diabetes and heart disease?
• Can we improve cybersecurity or build sensors to detect threats to our safety?
• How do we protect and enhance our supply of land, air, water and food?




























A bold vision: Healthy people on a healthy planet
Health, sustainability and security — these are the three core areas where we are making a difference. By harnessing the natural design rules of life on this planet and translating discoveries into the clinic and marketplace, we are finding new solutions to today’s complex challenges.


“At the Biodesign Institute, we are committed to catching disease before it catches us. We are finding creative and clean solutions for energy, air and water. We are inventing diagnostics and treatments that are accessible and affordable. We are growing next-gen researchers who will do the impossible.”
— Joshua LaBaer, MD, PhD
Executive director, Biodesign
Institute



Center for Applied Structural Discovery
Center for Biocomputing, Security and Society
Center for Bioelectronics and Biosensors
Center for Biomaterials Innovation and Translation

Center for Environmental Health Engineering



Center for Health Through Microbiomes

Center for Bioenergetics

Swette Center for Environmental Biotechnology
Center for Fundamental and Applied Microbiomics
Center for Molecular Design and Biomimetics


Center for Mechanisms of Evolution
ASU-Banner Neurodegenerative Disease Research Center

Virginia G. Piper Center for Personalized Diagnostics

Pathfinder Center

Center for Single Molecule Biophysics
Center for Sustainable Macromolecular Materials and Manufacturing
and continuing to grow together


Though Biodesign has particular research strengths in key topics such as infectious diseases, immunology, imaging and testing, environment, cancer, neuroscience and security, our areas of exploration encompass much more.
Our desire to improve health, safety and sustainability for people worldwide, along with our curiosity and diverse expertise, continuously push us to ask questions and apply knowledge to the many issues facing humanity.






Our diverse research centers are discovery spaces where scientists from different disciplines can join forces to focus on key issues, develop research methods and technology, answer critical questions, and improve health, sustainability and security for all.



The landscape of 21st century health care is undergoing a transformative shift, transitioning from a population-based approach to highly personalized medicine. With recent breakthroughs in unraveling the intricate workings of proteins, mapping the human genome and plotting the gut microbiome, new information is now at our fingertips — information that will lead to earlier detection of disease, precision treatments and the possibility of cures.

Featured capabilities:
Developing diagnostics to enable earlier detection of disease, including the identification of biomarkers and methods and devices to measure them.
Revolutionizing health care with cutting-edge nanotechnologies designed to address health issues at their source within the human body.
Creating new vaccines and therapies to battle and treat infectious diseases.
Identifying new ways to fight many types of cancer.







As COVID-19 threatened lives, livelihoods and wellbeing around the world, ASU met the challenges with speed, agility and teamwork. As part of ASU’s effort, Biodesign researchers, faculty, staff and students sprang into action, joining forces with the state, health care agencies, businesses and nonprofits in the epic battle against COVID-19.
Together, we quickly stood up a clinically approved and certified COVID-19 testing lab and developed the first saliva-based COVID-19 PCR test publicly
available in the southwestern U.S. We set up hundreds of testing sites throughout the state and partnered with state agencies to deliver more than 1 million vaccines. Biodesign scientists sequenced the virus’s genome and tracked variants, providing key data to monitor and predict the pandemic’s spread.
Though the initial shock of thepandemic may be behind us, researchers continue to tackle challenges that still lie ahead, from improving vaccines and tracking viral variants to understanding and treating long COVID.
With support from the National Science Foundation, ASU is building the world’s first compact X-ray free electron laser, or CXFEL. This oneof-a-kind, room-sized X-ray laser instrument will allow researchers to explore complex matter at atomic scale, providing high-speed movies of chemical reactions and molecules in action. To do this, the CXFEL will produce X-ray beams of incredibly short pulse durations — less than one millionth of a billionth of a second.

Because the CXFEL is a fraction of the size and cost of existing XFELs, more scientists will have access to this powerful tool. The facility will be available to national and international investigators from a wide range of scientific disciplines.




The applications for CXFEL technology cut across semiconductor design, quantum materials, medicine and more. For example, the CXFEL’s ability to make images and movies on a molecular scale could reveal how viruses attack cells or how drugs bind to target proteins. This paves the way for safer, more effective pharmaceuticals that could help fight both emergent and longstanding diseases.





Our planet faces an array of critical threats, including pollution, climate change, deforestation and the growing scarcity of food, energy and water resources.
At the Biodesign Institute, we confront these issues head-on, leveraging bold, nature-inspired approaches. Our interdisciplinary, solution-driven teams are dedicated to developing groundbreaking solutions that safeguard ourselves and our environment.

The ability to transform sunlight into energy — photosynthesis — is one of nature’s more remarkable feats. Understanding this process unlocks the potential to develop new forms of clean and abundant fuels. ASU scientists leveraged X-ray free electron laser (XFEL) technology to uncover the inner mechanics of photosynthesis. They used a technique called serial femtosecond crystallography, which was pioneered by Biodesign Institute researchers.
At the Biodesign Institute, we are committed to pioneering sustainable solutions rooted in nature’s wisdom, aiming to protect and rejuvenate our precious planet.



In another groundbreaking contribution, a team at the Biodesign Institute played a pivotal role in influencing the FDA’s decision to ban personal care products containing antimicrobials like triclosan and triclocarban. Our research, in conjunction with other institutions, revealed the potential health risks associated with prolonged exposure to these antibacterial agents, such as bacterial resistance and hormonal disruptions.
Another Biodesign team invented a membrane biofilm reactor that uses naturally occurring microorganisms to remove contaminants from drinking water, including nitrate, perchlorate and PFAS (per- and polyfluoroalkyl substances). All of these substances have been shown to cause health problems when they are consumed. PFAS are sometimes called “forever chemicals” because they can take thousands of years to break down in the environment.
Ensuring access to safe drinking water and sustainable energy sources in the face of climate changes.
Enhancing the efficiency of feedstock production for biofuels.
Pioneering the use of biocrust to combat blowing dust and diseases in arid desert environments.
Innovating green materials for manufacturing to reduce plastic waste.

Bioterrorism, nuclear terrorism, cyberterrorism, or the accidental or intentional import of exotic diseases are not the kinds of things we like to think about. Yet there’s no doubt that as a nation we must be prepared. Ensuring our troops have the technologies they need in the field to monitor and respond to threats is also a focus of our work at the Biodesign Institute.

Our researchers are equipping the medical and defense communities with the tools they need to monitor public health, improve early diagnostics and determine the best possible methods of treatment. Across the world, scientists are fighting a battle against new classes of infectious diseases and other biological threats. The ASU Biodesign Institute is operating on the front lines of that battle.
Biodesign Institute researchers are applying biological concepts to computer technologies to improve cybersecurity and solve software engineering problems. For example, they are using evolutionary computation tools to automatically fix software bugs and enhance security. And they are applying lessons learned from our immune systems to invent new cybersecurity solutions.
0 0 1 1 0 1 1
Featured capabilities:
Developing technologies to rapidly assess radiation absorption in individuals, which could save thousands of lives in the event of a nuclear incident.
Creating self-repairing software inspired by immune systems.
Advancing electrochemical microscopy, the foundation for major technologies such as batteries, fuel cells, chemical sensors, biological sensors, and methods of chemical analysis and corrosion prevention.
Monitoring wastewater to enable public health organizations to localize the source of an outbreak and take action to combat its spread.






We stand proudly as a globally recognized research institute within a university that leads the United States in innovation. Armed with our deep expertise in nature inspired innovation, the Biodesign Institute is poised to embrace whatever the future holds.